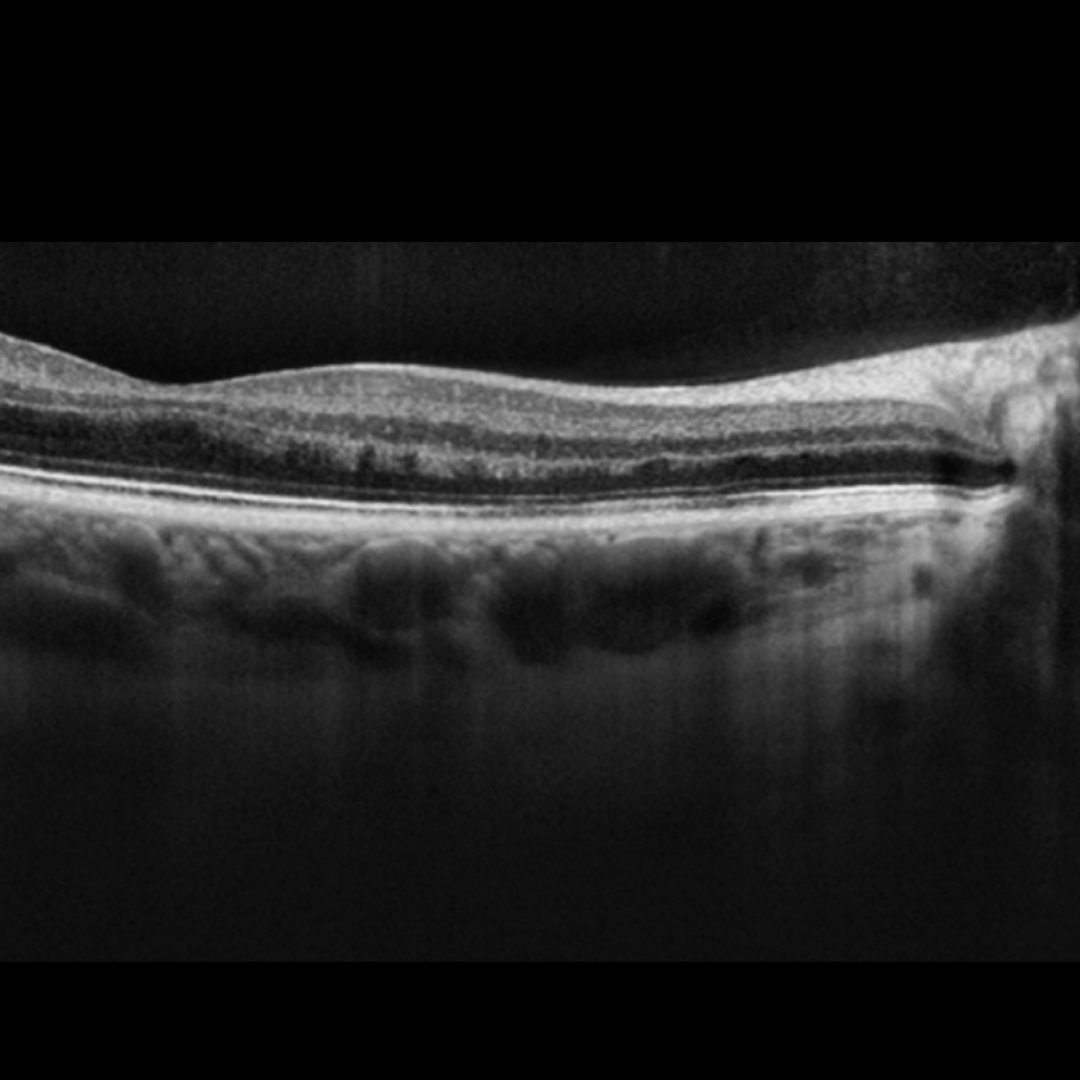

Overview
Acute macular neuroretinopathy is a rare condition most commonly found in young white females. Recent research suggests a microvascular aetiology. It is typically associated with non-specific flu-like illness, fever, or the use of oral contraceptives.
This condition is characterised by small paracentral wedge-shaped lesions oriented such that the apex of the lesion points towards the fovea. Paracentral scotomas are associated with the lesions. 54% of cases are bilateral.
The lesions are initially best seen on infra-red imaging but become more visible over days to weeks on examination and retinal photography.
OCT imaging through the lesions usually show disruption of the outer retina.
Case Examples
-
Case 1
A 17 year old Caucasian female with a 2 month history of visual disturbance. Prior to onset, the patient reports having a fever, nausea and a cough. She reports that the visual symptoms have decreased over time. Her medical history is unremarkable but she does report using the oral contraceptive pill.
Fundus photograph and red-free image (right eye)
More infoFundus photograph and red-free image (left eye)
More infoFundus autofluorescence images (right and left eye)
More infoCirrus OCT macular line scans (right - top, left - bottom)
More infoCirrus OCT Angiography (Right eye, 6 x 6mm) - Choriocapillaris
More info10-2 SITA Standard visual field
More info -
Case 2
A 29 year old Caucasian female complaining of a persistent spot in her left eye vision that resembles an after-image. She was recovering from an influenza A infection at the time the visual disturbance appeared. Visual acuity was 6/6 in the left eye. Testing with an Amsler grid allowed a small defect approximately 5 degrees temporal to fixation to be mapped out.
Differential Diagnosis
References
Bhavsar, KV. Lin, S. Rahimy, E. Joseph, A. Bailey Freund, K. Sarraf, D. Cunningham, ET. (2016) Acute macular neuroretinopathy: A comprehensive review of the literature, Survey of Ophthalmology, Volume 61, Issue 5, pp 538-565,


